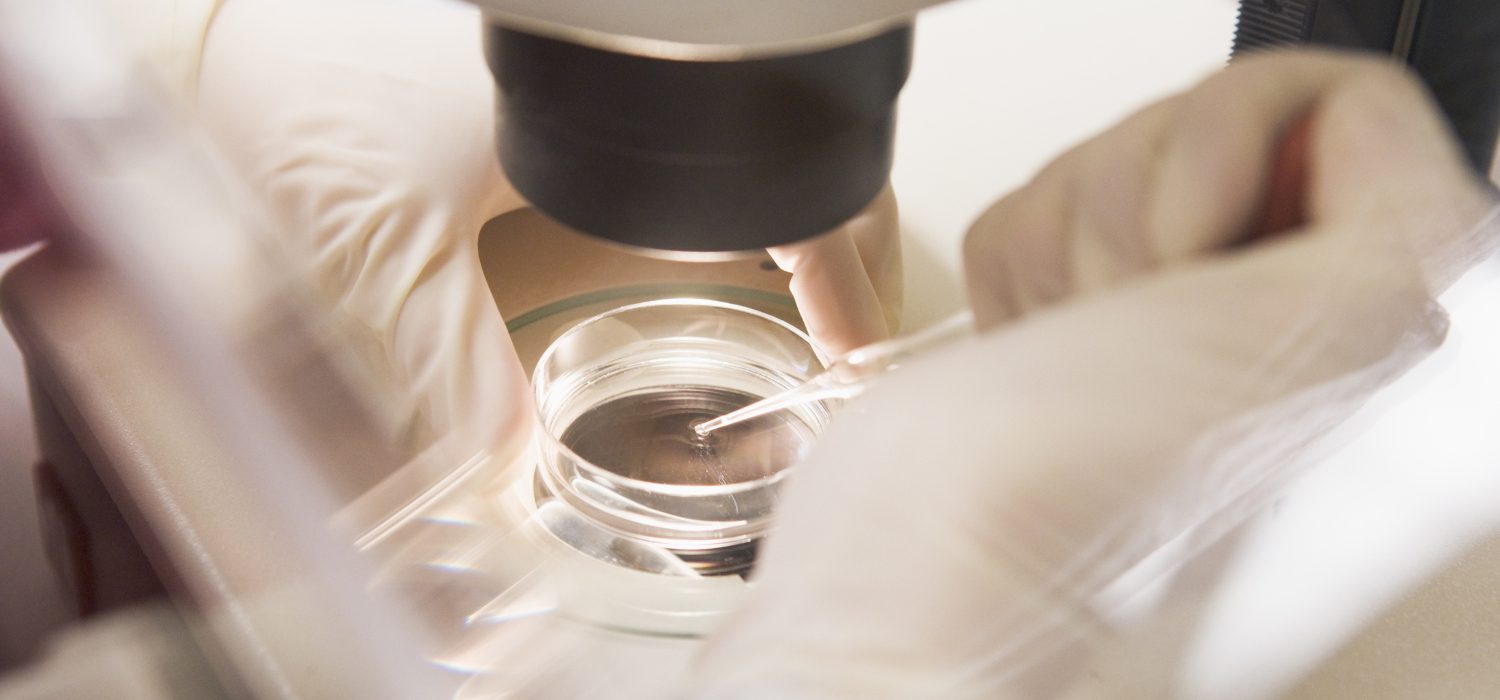
ivf lab denver

Follow our Socials
IVF with Uterine Didelphys – Kelsi’s Story
Trending Videos & Podcasts
Parenting
There’s a memory gap in early parenthood that we don't talk about – and it’s why these two mums are giving the baby book a digital revival
What is a digital baby book, and could it help you remember more of early parenthood? We're exploring the "memory gap", the pressure to document everything, and how modern memory-keeping can fit around real family life.
LISTEN NOWDonor Conception
Beyond the catalogue – what really matters when choosing a sperm donor?
When you first open a donor catalogue, what do you actually focus on, and is that where the real decision begins? In this episode, we explore what matters beyond filters, from genetic matching to those unexpected emotional turning points, helping you feel more confident as you navigate choosing a sperm donor.
LISTEN NOWSurrogacy
Things no one tells you about surrogacy family building, with Be Parent
A journey often spoken about in practical or (incorrectly) transactional terms, surrogacy myths and misconceptions can easily crop up. But behind every step is something much bigger. And it sits at the intersection of people, emotions, relationships and decisions that shape a family for life.
LISTEN NOWFertility
Surrogacy family building – navigating emotions & building bonds
What are the emotional effects of surrogacy for intended parents and surrogates? In this episode, Samantha Stacks from ACRC Global shares honest insights on navigating complex emotions, building trust and creating meaningful bonds throughout the surrogacy journey, from the first match meeting to post-birth.
LISTEN NOWFertility
Mini-series ep. 3: Challenging the endo status quo – Diagnosis myths
Feeling lost in the maze of endometriosis diagnosis? Hear directly from a specialist as we speak to Dr. Mona Orady and to debunk some common myths — covering why seeing a specialist matters, when to seek a second opinion, testing options beyond surgery, and practical steps to navigate information and get accurate answers.
LISTEN NOWFertility
Mini-series ep. 2: Challenging the endo status quo - Fertility myths
Does endometriosis mean you’ll struggle to get pregnant? And, does stage play a role? In this second episode, we're joined by Dr. Mona Orady to break down the facts, from how endometriosis staging relates to fertility, to IVF, egg freezing, and practical steps to take if you suspect endometriosis while trying to conceive.
LISTEN NOWFertility
Mini-series ep. 1: Challenging the endo status quo - Pain myths
Painful periods are often dismissed as “normal”, but when is pain a sign of something more? In the first episode of this mini-series, we speak to Dr. Mona Orady to unpack common endometriosis pain myths, from pain tolerance to unexpected symptoms.
LISTEN NOWFertility
Protocol, or pause? How to navigate a fertility journey when you feel like you’re running out of time
Feeling time pressure and fertility treatment anxiety? Listen as a Certified Integrative Fertility Coach shares how slowing down can help you move forward.
LISTEN NOW(Peri)menopause
Mini-series ep. 3: Menopause weight management toolkit - How can medicated support help?
Confused by hormones, weight changes and all the talk about GLP-1 medications? Envigore Prescriber Danny Chu breaks down how specialist medical support works in menopause, what really matters for long-term health, and why sustainable, personalised care beats quick-fix solutions every time.
LISTEN NOW(Peri)menopause
Mini-series ep. 2: Menopause weight management toolkit - How do I create lasting habits?
If your old routines no longer feel helpful in menopause, it’s not a lack of willpower. Certified hypnotherapist Matthew Leckie shares how thoughts, habits and behaviours shift during this stage of life, why hypnotherapy can help, and one simple mindset change to focus on when everything feels overwhelming.
LISTEN NOW(Peri)menopause
Mini-series ep. 1: Menopause weight management toolkit - What should my health priorities be?
Why do so many women say menopause makes them feel like a different version of themselves? Dr. Irina Jahn explains what’s really happening in perimenopause and menopause, how changes show up physically and emotionally, and which health priorities matter most right now, with compassionate guidance on what to do next.
LISTEN NOWFertility
Mini-series ep. 2: Where small details = big outcomes – Your IVF lab questions, answered
IVF success is, in huge part, built in the lab. In this episode, Eloise Edington speaks with Dr. Dana Ambler of Denver Fertility Care about what really matters inside a modern IVF lab in Colorado, from embryo culture to the small details that influence big outcomes.
LISTEN NOWFertility
Mini-series ep. 1: Who’s behind your fertility care? Meet the Colorado clinic helping demystify the conversation
What if the most important part of your fertility care isn’t the treatment — but who’s behind it? In this episode, Eloise Edington speaks with Dr. Dana Ambler of Denver Fertility Care, a leading fertility clinic in Denver, Colorado, about ownership, patient empowerment, and why clinic structure shapes care.
LISTEN NOWFertility
Mini-series ep. 3: Fertility without borders – One patient’s experiences, revealed
In this third and final episode of our mini-series powered by The Medical Travel Company, TRB Founder Eloise is joined by Seetal Savla, fertility advocate and TMTC Brand Ambassador, to share her real and raw experience navigating infertility and treatment in the UK.
LISTEN NOWFertility
Mini-series ep. 2: Fertility treatment in India – Myths, facts & what to expect
In this second episode of our mini-series powered by The Medical Travel Company, TRB Founder Eloise sits down with the brilliant Dr. Puneet Rana Arora to uncover what fertility treatment in India is really like. We'll separate myths from facts, and offering clear insights for anyone considering cross-border fertility care.
LISTEN NOWFertility
Mini-series ep. 1: Closing the gap – South-Asian egg donor shortages in the UK, and overcoming barriers to treatment
In this first episode in our mini-series, TRB Founder Eloise speaks with Dr. Rima Rajkhowa, Medical Director of Gynaecology & Fertility at The Medical Travel Company, to unpack a chronically under-discussed issue in reproductive care today — the shortage of South-Asian egg donors in the UK.
LISTEN NOWFertility
Considering IVF? Got questions about PGT-A testing? Get answers from fertility experts
IVF can feel overwhelming, and even more so when PGT-A and other acronyms start to come up in the conversation. Watch two leading fertility specialists explain what PGT-A testing shows, who might benefit, how it might fit into your treatment plan and much more.
WATCH NOWFertility
The $40 safety net – how this fertility insurance is changing the game for Gen-Zers
Gen Z is redefining what it means to plan for the future, starting with fertility. TRB Founder Eloise chats with FLORA Fertility Co-Founder Laura McDonald about the $40 safety net that’s making fertility insurance accessible, empowering, and totally built for the next generation.
WATCH NOWFertility
Does egg freezing affect future fertility? No, but here’s what to know if you’re planning
Possibly one of the biggest questions, if you’re considering treatment. In this episode, TRB Founder Eloise sits down with Dr. Shirin Khanjani, Consultant Gynaecologist, accredited subspecialist in reproductive medicine and surgery at Fitzrovia Fertility, to unpack.
LISTEN NOWFertility
An MD’s guide to navigating slow and no response to IVF stimulation
Slow response to IVF stimulation? Reproductive Endocrinologist Dr. Monica Best explains what a poor or slow ovarian response means, why it happens, and what can help — from protocol tweaks to emotional support. Listen now.
LISTEN NOW